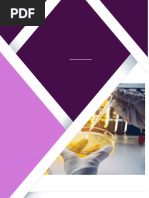

0% found this document useful (0 votes)
365 views18 pagesUnderstanding Human Senses and Responses
This document discusses the different human senses and how they function. It describes the sensory organs for touch (skin), smell (nose), taste (tongue), hearing (ears), and sight (eyes). It explains how each sense detects various stimuli through specialized receptor cells and sends messages to the brain. The document also covers vision defects, ways to correct them, limitations of the senses, and devices that can help overcome these limitations. Plant responses such as tropisms and nastic movements are also summarized.
Uploaded by
Nor Fadhilah ZainudinCopyright
© © All Rights Reserved
We take content rights seriously. If you suspect this is your content, claim it here.
Available Formats
Download as DOCX, PDF, TXT or read online on Scribd
0% found this document useful (0 votes)
365 views18 pagesUnderstanding Human Senses and Responses
This document discusses the different human senses and how they function. It describes the sensory organs for touch (skin), smell (nose), taste (tongue), hearing (ears), and sight (eyes). It explains how each sense detects various stimuli through specialized receptor cells and sends messages to the brain. The document also covers vision defects, ways to correct them, limitations of the senses, and devices that can help overcome these limitations. Plant responses such as tropisms and nastic movements are also summarized.
Uploaded by
Nor Fadhilah ZainudinCopyright
© © All Rights Reserved
We take content rights seriously. If you suspect this is your content, claim it here.
Available Formats
Download as DOCX, PDF, TXT or read online on Scribd